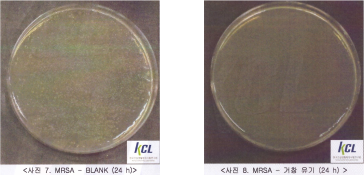

About SURA
For four generations, our artisans have preserved Korea’s sacred bronze craft, carrying its spirit into the modern age.

About SURA
For four generations, our artisans have preserved Korea’s sacred bronze craft, carrying its spirit into the modern age.


With use, Yugi deepens in color and meaning, growing more precious with time.
Since 1924

The Rituals of Our Artisans
At SURA, each day begins in stillness.
As our Yugi is made for life’s quiet rituals, our artisans begin with mindful breathing: a moment of meditation before creation.
A Legacy Recognized by the Nation



Chosen Worldwide
Used by Michelin-Starred Restaurants
Two Michelin Stars
One Michelin Star
Global Exhibitions & Presence

2023 Blue House Reception Event

2019 Milan Beopgo-Changsin Exhibition

Maison & Objet 2020 in Paris, France
Yugi: The Metal That Breathes

Scientific studies show that viruses are deactivated on surfaces containing more than 70% copper.
*The New England journal of Medicine (2020)

Composed of 78% copper and 22% tin, Yugi unites copper’s swift thermal conductivity with tin’s enduring stability — allowing it to maintain temperature naturally and gracefully.

In Geochang, Gyeongsangnam-do, Korea
In Geochang, where mountains meet rivers, we craft Yugi that carries the land’s quiet vitality and timeless strength.
Chef Ok Dong-sik's NY Dwaeji Gomtang Collection
Chef Ok Dong-sik's Black Spoon Challenge Collection